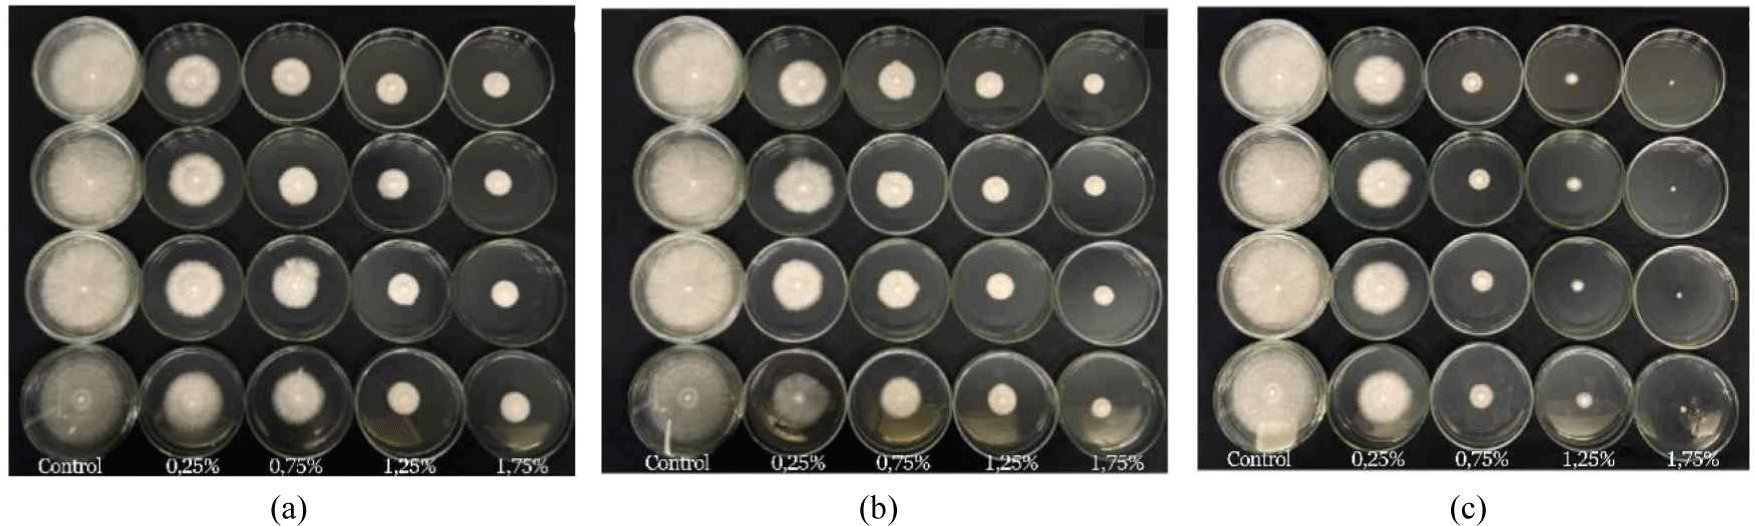
wood-54-1-63-g9
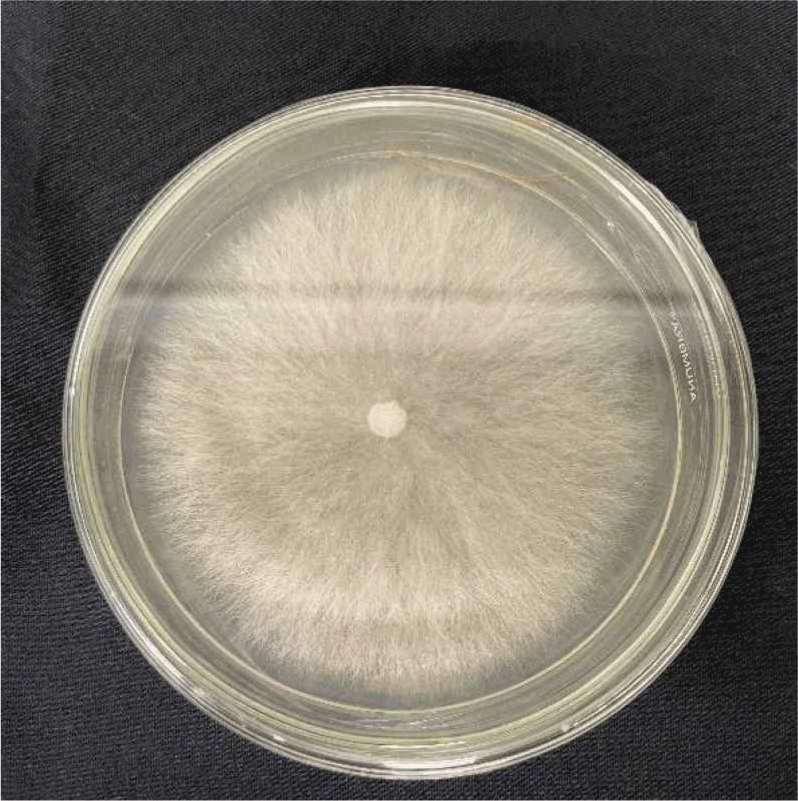
wood-54-1-63-g4

1. INTRODUCTION
In 2023, Indonesia produced 68.22 million cubic meters of roundwood, with acacian wood accounting for 45.61% of the total industrial forests (Badan Pusat Statistik [BPS], 2024). The island of Sumatra primarily dominated roundwood production at 46.1 million m3, followed by Kalimantan at 12.09 million m3 (BPS, 2024). In contrast to Sumatra, where acacia wood is comprised 62.13% of the total output, Kalimantan was dominated by mixed jungle wood types, accounting for 52% of total output. This trend was underscored by the State of Kalimantan’s production forests, which still rely on natural forests as their primary source. Mixed jungle wood falls under commercial category one (31 types) and commercial category two (55 types; BPS, 2024). The wood types outside of these categories were classified as lesser-known or less commonly used. Lesser-known wood types are often overlooked due to their low economic value and are not utilized for industrial purposes.
Research on lesser-known wood species continues to develop to find optimal uses and is expected to replace mixed forest wood. Iswanto et al. (2023) showed that Lophopetalum sp. wood has potential for development as a lightweight construction material and furniture. However, this wood has low resistance for termite attacks (Class IV). A study by Marbun et al. (2019) on four lesser-used wood types, including Octomeles sumatrana, Duabanga moluccana,Horsfieldia hellwigii, and Artocarpus odoratissimus Blanco, showed that these lesser-used wood as a raw material for pulp and paper production (Class II Quality; Marbun et al., 2019).
Another study on three lesser-used wood species, including Palaquium lanceolatum, Mezzettia leptopoda, and Sindora wallichii, indicated that white banana and sepetir wood are classified as strength class IV. In contrast, nyatoh wood is classified in strength class III and is suitable as a raw material for pulp and paper (Augustina et al., 2020). However, wood resistance to termite attack falls into durability class “0” due to damage being approximately 75% (Augustina et al., 2021). Another study on eight lesser-known wood species from five Apocynaceae genera, including E.aurantiaca, E. macrocarpa, E. sphaerocarpa, K. flavida, L. ternatensis, P. acuminata, P.rubra, and V. foetida indicated that the four lesser-known woods species, including E. macrocarpa, E. sphaerocarpa, K. flavida, and V. foetida are potential raw materials for pulp and paper (Quality Class II; Marbun et al., 2023).
These findings suggest that lesser-known wood species have potential as raw materials for pulp and paper production, respectively. However, as raw materials for construction and furniture, additional treatment is necessary to enhance their resistance to insect attacks. Optimal use of lesser-known wood can be achieved by converting it into other derivative products, one of which is wood vinegar.
Wood vinegar is produced from various raw materials, including apple tree branches (Liu et al., 2021), nipah fruit (Oramahi et al., 2022), bamboo vinegar (Arsyad et al., 2020), oil palm empty fruit bunches (Oramahi et al., 2019), sengon (Albizia chinensis; Arsyad et al., 2019; Basri et al., 2023), jelutung wood (Dyeralowii Hook; Oramahi et al., 2021), cocoa pod shells (Theobroma cacao L.; Desvita et al., 2022), apricot kernels, oak wood, and hazelnut shells (Kara et al., 2024).
Nurhaida et al. (2025) showed that wood vinegar could be used as an anti-termite treatment for particle boards. The quality of wood vinegar depends on raw material, duration of pyrolysis, and pyrolysis temperature. In addition, the concentration of wood vinegar also affects its effectiveness in inhibiting the growth of fungi and serves as an anti-termite agent. Wood vinegar contains several active compounds, such as 2-methoxy-phenol, 4-ethyl-2-methoxy-phenol, 4-ethyl-2-methoxy-phenol, 3,5-dimethoxy-4-hydroxytoluene, and creosol, which possess antifungal properties (Suprianto et al., 2023).
These compounds inhibit the growth of microorganisms, including wood-rotting fungi and wood-destroying insects like termites. Wood vinegar produced by the pyrolysis from various biomass sources has been used as an antifungal (Oramahi et al., 2024a; Santoso et al., 2023), antibacterial (Yıldızlı et al., 2024), anti-termite (Nurhaida et al., 2025; Oramahi et al., 2024b), and antioxidant (Xue et al., 2022).
To date, no study has investigated the use of Santiria griffithii wood to produce wood vinegar. S. griffithii is a lesser-known wood species, and there is little information regarding its suitability in wood vinegar production (Desvita et al., 2025). In the Sambas area of West Kalimantan, this wood is common and often used by small furniture businesses, which generates waste such as sawdust, boards, and wood pieces. This sawdust waste can be used as a raw material for wood vinegar (Desvita et al., 2025). However, this type of waste is rarely processed effectively. Using lesser-known wood like S. griffithii for wood vinegar production can increase the value added and reduce reliance on environmentally harmful synthetic chemicals.
Previous studies have shown that wood vinegar can inhibit the activity of several types of pathogenic fungi and wood-destroying insects; however, there are few studies examining the effectiveness of wood vinegar, particularly against Coptotermescurvignathus termites and Schizophyllum commune fungi. Therefore, this study investigated the potential of wood vinegar derived from S. griffithii wood as a natural preservative for protecting wood against attacks by these two destructive organisms.
2. MATERIALS and METHODS
S. griffithii wood was obtained from Semparuk District, Sambas Regency, C. curvignathus subterranean termites from Sungai Ambawang District, and S. commune fungus from the Forest Products Chemistry Laboratory, Faculty of Forestry, UNTAN. We also used potato dextrose agar (PDA; media grade for microbiology; Merck, Rahway, NJ, USA), spirits, aqua, 70% alcohol, amoxicillin antibiotics, and Whatman paper No. 1 (Whatman, Maidstone, UK).
The sample used in this study was passed through a 10-mesh screen and retained on a 14-mesh screen. The raw material was dried to achieve an air-dried sample with water content of 12% to 18% (Standar Nasional Indonesia [SNI], 2006). A sawdust sample (1 kg) was placed in the reactor sealed, and a thermocouple was installed. A series of condensers at different temperatures of 300°C, 350°C, and 400°C was used, with a pyrolysis time of 150 minutes. The smoke produced during pyrolysis in the reactor was directed to the condenser (Desvita et al., 2025). The gas that condensed into the wood vinegar was then directed into a wood vinegar container (Faisal et al., 2024).
C. curvignathus termites colony was obtained from dead and fallen trees in the Ambawang area, Kubu Raya Regency, West Kalimantan (Fig. 1). Parts of the trees attacked by termites were cut into several pieces to facilitate their transportation to the laboratory for conditioning for approximately three weeks before their use for testing. During conditioning, the humidity in the maintenance container was maintained by occasionally adding water.
The method for soaking the test paper in the concentration treatment was modified from Adfa et al. (2017). Whatman filter paper was cut to a diameter of 30 mm (Chieng et al., 2008), assigned a code based on the treatment, and weighed to obtain the initial weight before the wood vinegar concentration treatment. Five concentration levels were tested: 2%, 4%, 6%, 8%, and 10% (Table 1). The treated test paper served as the food source for termites during the test period. The material requirements for the concentration treatment were calculated using the following formula (%v/v):
| Concentration (%) | Liquid smoke concentration treatment requirements | |
|---|---|---|
| Wood vinegar (mL) | Solvent (mL) | |
| 2 | 0.2 | 9.8 |
| 4 | 0.4 | 9.6 |
| 6 | 0.6 | 9.4 |
| 8 | 0.8 | 9.2 |
| 10 | 1 | 9 |
Where V1 = Volume of wood vinegar required; V2 = Volume of solution to be produced; N1 = Initial concentration of wood vinegar; N2 = Concentration of wood of vinegar to be produced.
The concentration treatment, prepared according to the composition listed in Table 1, was then applied to the filter paper by soaking for 1 hour. Subsequently, the filter paper was dried at room temperature for approximately 24 hours, followed by heating in an oven for 1 h at 60°C. The sample was weighed to obtain its initial weight before feeding to the subterranean termite C. curvignathus.
Mortality testing was performed using the modified cellulose pad method (Addisu et al., 2014). Termite testing was conducted using five wood vinegar concentrations derived from S. griffithii, applied to Whatman filter paper at specified concentrations (Table 1), along with one control and four repetitions. Fig. 2 illustrates the termite test container used to observe the activity and level of consumption by termites. The container was specifically designed to maintain environmental conditions suitable for termites, thereby providing accurate test results.
The test container was 7 cm high and the diameter of the glass base was 5 cm. It was filled with approximately 15 g of sterilized sand that had been autoclaved for 1 h at a temperature of 121°C. The sand was moistened with approximately 4 mL of water. The stages of termite testing were as follows: (1) test paper treated with a wood vinegar concentration was placed in the test glass, (2) subterranean termites were introduced into test glass, totaling 33 termites (30 workers and three soldiers), and (3) the test glass was placed in a humid container equipped with cotton and water to maintain humidity. The experiment was conducted in four repetitions over 21 days, with checks every 3 days to collect dead termites and prevent fungal growth that could harm other living termites, while also controlling the humidity conditions of the sand media. The parameters used in this study included termite mortality and the weight loss of the test paper. Termite mortality and the weight loss of the test paper were calculated after the 21-day testing period. Mortality was calculated using the following formula (Arinana et al., 2024):
The effectiveness of the wood vinegar concentration treatment was assessed based on the observed termite mortality and categorized accordingly, as described in Table 2.
| Mortality (%) | Activity level | Symbol |
|---|---|---|
| M ≥ 95 | Very strong | A |
| 75 ≤ M & 95 | Strong | B |
| 60 ≤ M & 75 | Fairly strong | C |
| 40 ≤ M & 60 | Moderate | D |
| 25 ≤ M & 40 | Slightly weak | E |
| 5 ≤ M & 25 | Weak | F |
| M & 5 | Inactive | G |
The weight loss of the test paper was measured after 21 days of testing to determine the level of C. curvignathus termite consumption. Before weighing, the test paper sample was cleaned of the attached dirt from termite activity. The samples were then oven-dried at 60°C for 1 h, placed in a desiccator for approximately 15 minutes, and weighed to obtain the oven-dried weight of the samples. The percentage of weight loss was calculated using the following formula (Hadi et al., 2018; Nkogo et al., 2022; Zalsabila et al., 2024).
The weight loss data obtained was compared with the classification of the level of resistance to termite attacks, as explained by Sornnuwat et al. (1995; Table 3). This level of resistance was used to describe the anti-termite properties of wood vinegar.
| Weight loss (%) | Resistance level | Symbol |
|---|---|---|
| 0 | Very resistant | A |
| 1–3 | Resistant | B |
| 4–8 | Moderately resistant | C |
| 9–15 | Slightly resistant | D |
| > 16 | Not resistant | E |
Data from Sornnuwat et al. (1995).
The feeding rate, measured by test paper consumption, allows comparison across tests with varying wood vinegar concentrations. Assuming termite mortality progresses linearly, Equation (4) was used to calculate feeding rates (Chotikhun et al., 2024; Hadi et al., 2014).
A total of 39 g of PDA was dissolved in 1,000 L of distilled water and homogenized using a magnetic stirrer and heating on a hot plate until the PDA solution was homogeneous. Subsequently, 0.04 g of the amoxicillin antibiotic was added and homogenized, followed by sterilization using an autoclave at a temperature of 121°C and a pressure of 1 atm for 15 min. Images of PDA media used for fungal testing is shown in Fig. 3.
The propagation of S. commune is based on the method of Suresh et al. (2019). S. commune fungus was obtained from the Forest Products Chemistry Laboratory at the Faculty of Forestry, Untan and propagated using fresh PDA medium. S. commune fungus was propogated using an ose needle to transfer and place S. commune in fresh PDA medium in a sterile Petri dish. After inoculation, the plates were incubated at a temperature of 22°C–32°C for 2–7 days. Fig. 4 shows the mycelium of fungal isolation after being rejuvenated for research purposes.
The fungal activity was tested using a modified method (Suresh et al., 2019). Fungal growth media used PDA in a petri dish containing wood vinegar concentrations of 0.25%, 0.75%, 1.25%, 1.75%, and control (Table 4). Material requirements for concentrations were calculated using the formula (%, v/v) as referenced in Suprianto et al. (2023) and Equation (1). Furthermore, a 7-day-old S. commune fungal isolate was obtained with a diameter of 5 mm using a sterile needle and placed in the middle of a petri dish containing PDA media that underwent concentration treatment. The Petri dish was then sealed, and the edges of the Petri dishes were covered with plastic wrap, and stored in an incubation room. The fungal growth was observed daily by measuring the diameter of the growth. Observations ceased after 7 days or when the fungal growth in the control filled the Petri dish. Incubation was carried out at a temperature between 22°C and 32°C for 2–7 days. All testing activities were conducted in a closed room, using a laminar airflow device to maintain sterility.
| Concentration (%) | Wood vinegar (mL) | PDA (mL) |
|---|---|---|
| 0.25 | 0.025 | 9.975 |
| 0.75 | 0.075 | 9.925 |
| 1.25 | 0.125 | 9.875 |
| 1.75 | 0.175 | 9.825 |
Data used to determine anti-fungal activity (AFA) values were obtained by measuring the growth of fungi mycelium on the seventh day after inoculation or the last day of testing. Measurements are made using digital calipers. Two perpendicular lines are drawn at the bottom of the Petri dish to calculate the average size of fungal growth, which was then determined using formula 5. Fig. 5 illustrates the method used for measuring fungal growth. This process involves periodically measuring the growth of mycelium colonies in both the vertical and horizontal sections to evaluate the rate of fungal growth. The average growth of fungi is calculated using the following formula.
P = average fungal growth, d1 = vertical growth, d2 = horizontal growth.
The calculation of the AFA value references the measurement method (Gothandapani et al., 2015). The AFA data used the average diameter from the last day of observation. The AFA formula is as follows.
AFA = antifungal activity (%); A = control mycelial growth (mm); B = initial mycelial size at incubation (mm); C = mycelial growth in treatment media (mm).
After calculating the AFA value, we assessed the effect of wood vinegar S. griffithii wood concentration treatment on the growth of S. commune fungus. This was then compared with the antifungal activity classification data (Table 5).
| No | Antifungal activity (%) | Activity level |
|---|---|---|
| 1 | AFA > 75 | Very strong |
| 2 | 50 & AFA ≤ 75 | Strong |
| 3 | 25 & AFA ≤ 50 | Moderate |
| 4 | 0 & AFA ≤ 25 | Weak |
| 5 | 0 | Inactive |
The experimental design for wood vinegar testing of S. griffithii wood against subterranean termites, C. curvignathus, and S. commune fungi utilized factorial experiment in a completely randomized design. The first factor was wood vinegar pyrolysis temperature, and the second factor was wood vinegar concentration (2%, 4%, 6%, 8%, and 10%) for anti-termite effects, whereas for AFA, the concentrations used were 0.25%, 0.75%, 1.25%, and 1.75%), with four replicates. Data on the inhibition of anti-termite and AFA were analyzed using analysis of variance. When significant differences among treatments were detected, Duncan’s multiple range test (DMRT) was applied at a 5% significance level. Data analysis was performed using SAS version 9.13 (SAS Institute, Cary, NC, USA).
Linear regression analysis was employed to evaluate the effect of wood vinegar concentration on termite mortality and filter paper weight loss, while correlation analysis was applied to examine the relationship between wood vinegar concentration and both response variables. The simple regression model is expressed as Y = a + bx, where Y represents the dependent variables (termite mortality and filter paper weight loss), a denotes the constant, b is the regression coefficient, and x represents the independent variable (wood vinegar concentration).
3. RESULTS and DISCUSSION
In this study, we demonstrated that higher pyrolysis temperatures and concentrations of S. griffithii wood vinegar increased termite mortality. In untreated samples, termite mortality was low, at 14.40 ± 2.62%. Termite mortality rate with wood vinegar increased significantly. Pyrolysis temperatures of 300°C and 350°°C and wood vinegar concentrations of 8% and 10% resulted in 100% termite mortality. This indicates that higher concentrations of wood vinegar are highly toxic to termites. Interestingly, wood vinegar prepared at a pyrolysis temperature of 400°C was even more effective, causing 100% termite mortality at a concentration of just 6%. This suggests that wood vinegar becomes more toxic to termites when produced at higher temperatures, even in smaller amounts (Table 6).
The increase in termite mortality, along with the rise in concentration and pyrolysis temperature, indicates that S. griffithii wood vinegar contains effective toxic compounds, including acid derivatives, phenols, carbonyl derivatives, and other volatile compounds identified by gas chromatography–mass spectrometry (GC-MS) and are suspected to have toxic properties against termites (Desvita et al., 2025). These findings are in line with those of Zhang et al. (2020), who reported that phenolic compounds are active substances with antimicrobial and insecticidal effects. The mechanism by which phenolic compounds function as insecticides involves entering the insect’s body through the respiratory system, weakening the nervous system and damaging the respiratory system (Adfa et al., 2020). Consequently, this incapacitates the insects’ ability to breathe, ultimately leading to their death.
The results of the termite mortality tests indicated that 8% and 10% wood vinegar effectively killed termites at all temperatures (300°C, 350°C, and 400°C), achieving 100% mortality. Oramahi et al. (2023) demonstrated a similar findings, where wood vinegar from other biomass sources, such as medang wood (Cinnamomum sp.) resulted in high termite mortality at the same concentration (8%). Notably, 100% mortality was recorded in wood vinegar at pyrolysis temperatures of 370°C, 400°C, and 430°C. Increasing the concentration of wood vinegar significantly enhanced termite mortality, particularly at a pyrolysis temperature of 400°C, where phenolic compounds, acid derivatives, and carbonyl derivatives appeared to work together synergistically to create toxic effects. Our findings are in line with those of Xin et al. (2021), who reported that phenolic compounds in wood vinegar possess poisonous properties, positioning them as potentially environmentally friendly insecticides.
Overall, increasing the concentration of wood vinegar at all pyrolysis temperatures led a significant increase in termite mortality and a reduction in weight loss in the test paper caused by the termite damage. Concentrations of 6%, 8%, and 10% yielded complete mortality (Fig. 6). At higher concentrations, particularly at pyrolysis temperatures of 400°C, the weight loss of the test paper dropped sharply to 13.65 ± 1.78, which is considered less resistant (symbol D). Therefore, wood vinegar concentration was directly correlated with reduced paper weight loss. At a concentration of 10%, weight loss of paper at both 350°C and 400°C was approximately 13% (Fig. 7). A study by Suprianto et al. (2023) demonstrated that the application of durian wood vinegar (Durio sp.) at 450°C with a 6% concentration resulted in 100% mortality of C. curvignathus.Oramahi et al. (2014) reported that the higher the concentration of wood vinegar from Vitexpubescens, the greater the mortality of C.curvignathus termites and the less the weight loss of filter paper. Fig. 8 illustrates the conditions of the test paper after exposure to C.curvignathus subterranean termites.



The reduction in the weight of the test paper is attributed to the capacity of the wood vinegar to safeguard the test paper against termite attacks. Compounds found in wood vinegar, such as phenol, acid, and carbonyl, act as inhibitors of cellulose-digesting enzymes in termites (Nurhaida et al., 2025).
This study demonstrates that wood vinegar derived from S. griffithii effectively protects test paper from termite damage, with lower concentrations offering maximum protection (Fig. 8). These findings align with those of Varma et al. (2018), who indicated that increasing the pyrolysis temperature produced volatile compounds that were more effective in diminishing enzymatic activity in termites, thus mitigating damage to the targeted material. The relationship between the mortality of C. curvignathus termites and the weight loss of test paper treated with S. griffithii wood vinegar demonstrated an inverse correlation; specifically, as the concentration and pyrolysis temperature increased, the weight loss of the test paper decreased. The findings are supported by the chemical composition of wood vinegar generated at three distinct pyrolysis temperatures (300°C, 350°C, and 400°C). Results of GC-MS analysis indicated that phenolic and carbonyl compounds considerably affected the insecticidal efficacy (Desvita et al., 2025).
The termite feeding rate was also analyzed using the total weight of the filter paper consumed per total number of termite individuals per day, assuming an equal rate of consumption. The results indicated a decrease in the feeding rate of filter paper consumption by termites (Table 6). Differences in pyrolysis temperature and the concentration of wood vinegar administered affected the termites’ feeding rate. These findings are consistent with those reported by Arinana et al. (2012) and Hadi et al. (2021) who demonstrated that raw material influences termite feeding rate. This is due to variations in the chemical components of the raw material. Protozoa found in the termite digestive systems can survive in the presence of cellulose (Kanai et al., 1982). However, the presence of other components such as acids and phenols in wood vinegar can reduce the feeding rate of termites because these components cause termite mortality. This aligns with studies showing that termite mortality reduces the feeding rate of C. curvignathus Holmgren termites (Chotikhun et al., 2024). Additionally, the feeding rate was influenced by the termite species. Coptotermes formosanus and Reticulitermes speratus termites consumed the sapwood of Pinus densiflora at rates of 0.0961 and 0.0737 mg per termite per day, respectively (Yoshimura et al., 2003). For C. formosanus, feeding activity increased as mortality decreased at the same concentration (Yoshimura et al., 2003).
Phenolic compounds and their derivatives 2-methylphenol and 3-methylphenol were consistently found in high concentrations across all pyrolysis temperatures (Desvita et al., 2025). According to Ouattara et al. (2023), compounds possess toxic properties for insects, leading to increased termite mortality and more effective protection of organic materials. Phenol in wood vinegar pyrolysed at 400°C exhibited a more significant synergistic effect with carbonyl compounds, thereby hastening termite death and reducing the weight loss of the test paper. At 350°C and 400°C, carbonyl compounds such as 2-pentanone and 4-hydroxy-4-methyl-were predominant. Adfa et al. (2017) indicated that primary compounds in wood vinegar, including phenol, acids, and carbonyl compounds, function as anti-termite agents. The presence of larger carbonyl compounds in this investigation was directly correlated to the reduction in paper damage, as these compounds disrupted Enzymatic activity of termites. Varma et al. (2018) demonstrated that pyrolysis at elevated temperatures yields more stable and effective chemical compounds than insecticides, as evidenced by decreased termite mortality and enhanced protection against organic matter. The application of wood vinegar to filter paper effectively resulting in termite mortality demonstrates its potential as a wood preservative when applied to the surface of wood materials. This finding also suggests that wood vinegar could be utilized as a soil treatment to mitigate termite infestations.
The influence of wood vinegar on the mortality of C. curvignathus termites across different pyrolysis temperatures and concentrations is presented in Fig. 6. The correlation coefficients between S. griffithii vinegar concentration and termite mortality at 300°C, 350°C, and 400°C are 0.966, 0.957, and 0.872, respectively, indicating a strong and positive relationship (p < 0.05). Similar findings have been reported by Oramahi et al. (2023).
The simple regression equations and coefficients of determination for the effect of wood vinegar concentration on termite mortality at pyrolysis temperatures of 300°C, 350°C, and 400°C are Y = 5.555 x + 17.316 and 0.933, Y = 9.091 x + 16.883 and 0.916, and Y = 21.769 x + 15.714 and 0.760, respectively. These models demonstrate that increasing wood vinegar concentration consistently enhances C. curvignathus mortality. The results aligned with those of Oramahi et al. (2023), who observed higher concentrations of wood vinegar derived from medang wood (Cinnamomum sp.) significantly elevated termite mortality.
The impact of wood vinegar on the weight loss of filter paper caused by C. curvignathus termites at various pyrolysis temperatures and concentrations are illustrated in Fig. 7. The correlation analysis revealed coefficients of 0.919, 0.870, and 0.860 between S. griffithii vinegar concentration and filter paper weight loss at 300°C, 350°C, and 400°C, respectively, signifying a robust positive correlation (p < 0.05). These findings are consistent with those of Oramahi et al. (2023). Regression equations, and coefficients of determination describing the relationship between wood vinegar concentration and filter paper weight loss at 300°C, 350°C, and 400°C were Y = 67.272 x – 8.780 (R2 = 0.844), Y = 58.459 x – 7.999 (R2 = 0.759), and Y = 55.564 x – 7.815 (R2 = 0.740), respectively. These equations indicate that higher concentrations of S. griffithii vinegar correspond to reduced filter paper weight loss, reflecting diminished feeding activity of C. curvignathus.
The correlation between vinegar pyrolysis temperature and weight loss reduction was influenced by termite mortality, as surviving individuals continued to consume filter paper, thereby contributing to substantial weight decreases. As shown in Fig. 7, treatment with vinegar concentrations ranging from 2.0% to 10.0% resulted in reductions of 13.02%–55.64% in filter paper weight. These findings are consistent with those of Oramahi et al. (2023), who reported that wood vinegar derived from medang wood (Cinnamomum sp.) at concentrations of 2.0% to 8.0% decreased filter paper weight loss by 11.99%–64.73% when tested against C. formosanus.
Both higher pyrolysis temperatures and increased wood vinegar concentrations greatly improved the ability to stop the growth of S. commune fungus. When wood vinegar was produced at a high temperature (400°C), it completely prevented fungal growth, even at a low concentration of 1.75%. At lower temperatures (300°C and 350°C), the same concentration only inhibited fungal growth by 76.78% and 83.50%, respectively. In summary, using wood vinegar made at 400°C and a concentration of 1.75% is highly effective at stopping S. commune fungus from growing, according to the statistical analysis (Table 7). This implies that an increase in pyrolysis temperature increases the active ingredients in wood vinegar, making it more effective against fungal growth (Fig. 9).
Previous investigations have proposed that phenolic compounds derived from lignocellulosic biomass are likely the main contributors to the antifungal efficacy of wood vinegars (Oramahi et al., 2010; Suprianto et al., 2023). The results of this study are consistent with previous research demonstrating that increasing the concentration of wood vinegar significantly inhibits the growth of S. commune fungi. This can be attributed to the bioactive compounds in wood vinegar, such as phenols, organic acids, and carbonyl compounds with potent antimicrobial properties (Permana et al., 2021). A temperature of 370°C at a concentration of 10% inhibited 100% of the growth of S. commune fungi. The mechanism of action of these compounds in inhibiting fungal growth is complex. Several recent studies have shown that phenolic compounds can damage the integrity of fungal cell membranes, causing cytoplasmic leakage and disruption of cellular metabolic processes (Lee et al., 2019).
The increased efficacy of fungal growth inhibition observed at elevated pyrolysis temperatures can be ascribed to the formation of more complex and stable aromatic compounds under such conditions. These compounds typically demonstrate enhanced antimicrobial activity compared to those generated at lower temperatures (Guimarães et al., 2014).
The results of the GC-MS analysis indicated that S. griffithii wood vinegar contains complex chemical components, with phenol being the predominant component at various pyrolysis temperatures (Desvita et al., 2025). Consistent presence of phenol and its derivatives (such as 2-methylphenol, 3-methylphenol, and 2-methylphenol) suggests that lignin, the primary component of wood, is effectively degraded during the pyrolysis process. Furthermore, the detection of compounds such as 2-pentanone, 4-hydroxy-4-methylcyclopentenone, and other derivatives suggests the decomposition of cellulose and hemicellulose (Desvita et al., 2025). These compounds inhibit the growth of S. commune fungi.
Phenolic compounds and their derivatives exhibit pronounced antifungal activity. Their mechanism of action involves the degradation of the fungal cell membrane, inhibition of critical enzymes and disruption of cellular metabolism (Guimarães et al., 2014). Moreover, carbonyl compounds can interact with proteins and nucleic acids in fungal cells, thus interfering with cellular function and hindering their growth (Mansur et al., 2023). Numerous studies have demonstrated that certain carbonyl compounds exhibit significant antifungal activity, particularly when combined with phenolic compounds (Mansur et al., 2023). In addition, owing to their reactive chemical structures, cyclopentenone derivative compounds show promise as antimicrobial agents (Gama et al., 2024). They can interact with proteins and lipids in fungal cells, leading to cell damage and cell death (Lee et al., 2019).
Besides phenol, carbonyl, and cyclopentenone derivative compounds, acid compounds inhibits the growth of S. commune fungi (Adfa et al., 2020). Acetic acid has the capacity to decrease the pH level within the environment, which is conducive to fungal growth, thereby establishing conditions detrimental to optimal fungal development (Mansur et al., 2023). These acidic conditions may have inhibited the activity of crucial enzymes within fungal cells and disrupt standard metabolic processes (Turecka et al., 2018). Therefore, it was essential to determine the antifungal activity of S. griffithii wood vinegar is influenced not only by the presence of individual compounds but also by the synergistic interactions among various constituents. The amalgamation of phenol, acids, carbonyl compounds, and cyclopentenone derivatives in S. griffithii wood vinegar possesses the potential to augment the efficacy of inhibiting the growth of S. commune fungi (Desvita et al., 2025).
Overall, the wood vinegar prepared from S. griffithii was found to be a strong antifungal agent in laboratory tests. When produced at a pyrolysis temperature of 400°C and used at a concentration of 1.75% completely inhibited the growth of S. commune fungus. At a lower pyrolysis temperature of 350°C, a concentration of 1.25% inhibited fungal growth by 75.39%. Thus, using wood vinegar at a 1.25% concentration and 350°C is optimal for reducing S. commune fungus growth in lab settings.
4. CONCLUSIONS
Wood vinegar produced from the lesser-known wood S. griffithii is highly effective at controlling both the termite C. curvignathus and the fungus S.commune. We demonstarted that increasing the pyrolysis temperature and the concentration of wood vinegar leads to higher termite death rates. When vinegar was produced at 400°C and used at a concentration of 6% or higher, it resulted in 100% termite mortality. Similarly, higher pyrolysis temperatures improved the vinegar’s ability to inhibit the growth of S. commune with complete inhibition (100%) achieved at 400°C and a concentration of 1.75%. Overall, S. griffithii wood vinegar shows strong promise as a eco-friendly wood preservative, with a temperature of 400°C being the most effective for controlling both C. curvignathus termites and S. commune fungi.